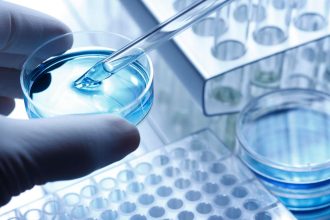

Markets
Editor's Top Picks
Your one-stop resource for personal news and tips.
More form Markets
Dollar in demand as Powell confirms hawkish stance
Investing.com - The U.S. dollar traded higher in the early European session Thursday, adding to…
Qiming-Backed AI Drug Discovery Startup Insilico Medicine Files For Hong Kong IPO
Insilico Medicine, a Hong Kong and New York-based company that uses AI for drug discovery,…
Shiba Inu Raises Red Flags, Monero and VC Spectra Join the Market Uptrend
Disclaimer: The text below is a press release that is not part of Cryptonews.com editorial content.Shiba Inu…
Nike’s Earnings Are Today. Wall Street Is Wary.
Wall Street has muted expected heading into Nike’s earnings report, as analysts fret over how…
LVMH chief Bernard Arnault, daughter embark on China tour
2/2 © Reuters. FILE PHOTO: Bernard Arnault, Chairman and Chief Executive Officer of LVMH Moet…
Dollar near 7-month high to yen on policy split; yuan snubs PBOC
By Kevin Buckland TOKYO (Reuters) - The U.S. dollar hovered near a more than seven-month…
Felons’ Bitcoin Sales Are Money Laundering
Russia’s Supreme Court has ruled that criminals’ Bitcoin (BTC)-to-fiat trades can be considered money laundering.Per…
This Top-Performing Small-Cap Manager Is Betting Big on China
Vivek Tanneeru understands why investors are avoiding China. Blame it on lackluster post-Covid growth and…
Washington state plans to mandate Tesla’s charging plug -official
© Reuters. FILE PHOTO: A Tesla super charger is shown at one of the company's…
Oil prices fall on concerns of slow fuel demand, weak China data
By Yuka Obayashi TOKYO (Reuters) -Oil prices fell on Thursday, paring some of the previous…
Analysis-Dollar drought haunts frontier economies
By Duncan Miriri and Marc Jones NAIROBI/LONDON (Reuters) - As Pakistan spiralled into crisis this…
MicroStrategy Acquires Additional $347 Million in BTC
Michael Saylor's MicroStrategy has added an additional 12,333 Bitcoin to its portfolio, in the last…
J&J’s $8.9 billion talc settlement faces US bankruptcy test
© Reuters. FILE PHOTO: Bottles of Johnson's baby powder are displayed in a store in…
Oil steadies after big jump as U.S., Chinese economic cues loom
Investing.com -- Oil prices kept to a tight range in Asian trade on Thursday, retaining…
UK Law Commission Calls for Special Legal Framework for Crypto as Collateral
The Law Commission of England and Wales has recommended a national legal framework tailored to…